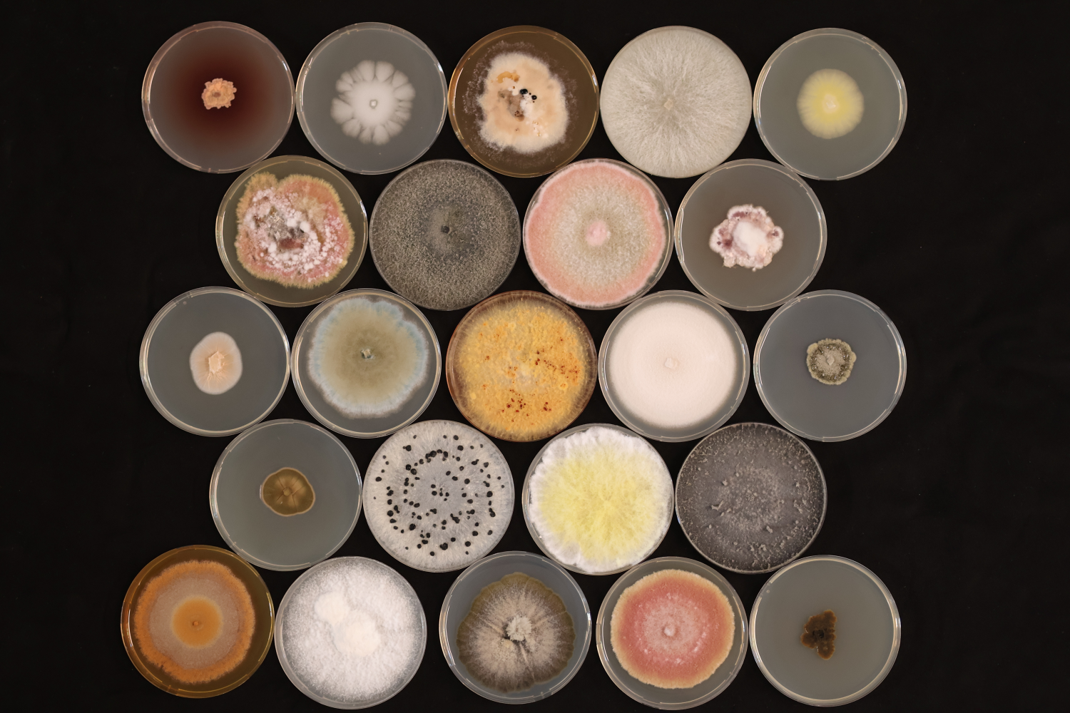

This lecture from the University of Göttingen’s public lecture series (“Ringvorlesung”) explores how climate change is driving the emergence and spread of new tree diseases. It examines how rising temperatures, drought stress, altered precipitation patterns, and extreme weather events influence pathogen biology, host susceptibility, and pest dynamics. The lecture also discusses case studies, monitoring approaches, and strategies for adapting forest and urban tree management to a rapidly changing climate.
Keywords: Climate change, tree diseases, forest health, emerging pathogens, adaptation strategies
Note: The video is in German.
- Source: Urban Tree Guard

Urban trees are essential for healthier cities—improving air quality, reducing heat, and supporting biodiversity. Yet, they face increasing threats from climate change, soil degradation, and pests.
COST Action CA20132 Urban Tree Guard brings together over 150 partners from 40 countries to protect urban trees through research, innovation, and collaboration. By developing cutting-edge solutions, we aim to enhance tree resilience and biosecurity.
- Source: Urban Tree Guard